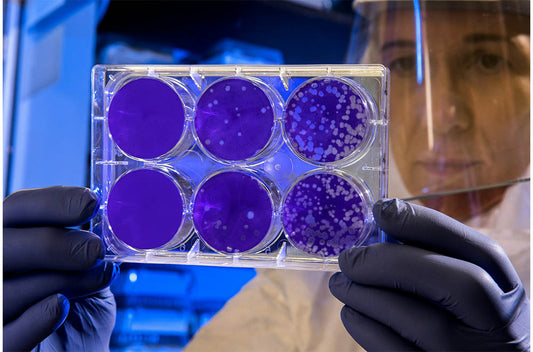

Featured Nature Strategy Reports
Flexible options to suit your needs,
from off-the-shelf to fully customized collaborations
Coming Soon
Frequently Asked Questions
You can choose one of two reports.
- Global landscape report
- Full report including the global landscape section, organisation profiling and peer benchmarks and collaboration profiling
Reports consist of analytical sections below - items below are a sample of the content for each report. This list is not exhaustive and other analysis is included.
Landscape of the impact of research
- The top 5 cities in the world
- The top 10 research institutes
- The top 10 funding organisations
- The top 20 research institutes receiving funding by grant amount
- The top 3 SDG
Organisation profiling and peer benchmarks
- Your organisation’s profile
- Comparisons of your research performance against five of your selected peers
- The top journals where researchers are publishing and the impact of their work
- Breakdown of research by research fields – allowing you to identify gaps
- Your top researchers
Understanding the collaboration landscape globally and for your institution
- Collaboration profiling (domestic, international and non-collaboration) and the associated impact
- The top 10 domestic and international collaborators
The report also includes an introduction, top takeaways, conclusions and recommendations and a methods section.
You will need to create an account to use the online shop for Nature Strategy Reports. The account ensures that we are able to:
- provide confirmation of your order,
- we can contact you to establish the peers for benchmarking purpose
- we can deliver the report to you
Further detail regarding user accounts can be found in the T&Cs.
Upon receiving your order, one of our team will be in touch with you to determine who are the five peers you would like to benchmark against in the report.
If you are unsure as to who those peers should be, we will take a consultative approach and provide some suggested benchmarks based on your feedback.
Yes at the checkout simply select “Invoice” as the payment option at the checkout. An invoice will be generated and sent to your email address.
Tax is already included in the pricing.